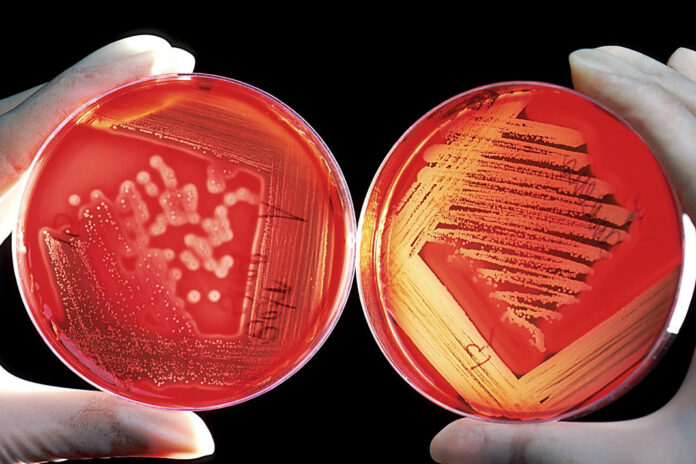
Dogum-sırasındaki-enfeksiyona-dikkat

Anne adayları bu yazımıza dikkatli okumanızı istiyoruz. Anne adaylarını bekleyen tehlikelerden biri kadının anal ve vajen bölgesine yerleşen bakteri Grup B Streptekoklar (GBS) dir. Eğer ihmal edilirse doğum esnasında anneden çocuğa bu bakteri geçerse bebeklerde ciddi problemler çıkmaktadır
Grup B Streptekokların bakterisi sağlıklı bir kadında görülme olasılığı yüzde 15 ile 40 arasındadır. Basit bir test ile bunun var olup olmadığı anlaşılmaktadır
Her 1000 doğumdan birinde bu enfeksiyona bağlı olarak ciddi komplikasyonlar meydana gelmektedir. Nadir bir enfeksiyonda olsa bebeğe bulaşan bu bakteri çok ciddi zararlara sebep olabilmektedir
GBS Olduğunu Nasıl Anlaşılır?
Bu test hamileliğin 35–37’nci haftalarında yapılmakta. Farklı bir dönemde yapılırsa enfeksiyon olup olmadığı pek anlaşılmamaktadır. Test sonucu 2 gün içinde çıkmakta
GBS Anneye Nasıl Bulaşıyor?

GBS bu bakteri vajen ve bağırsağa yerleşmekte ve çoğalmakta. Cinsel yolla bulaşmamaktadır. Anne de herhangi bir belirti ve şikâyet gözükmemekte.
Peki GBS Testi Pozitif Çıktığında?
Her annede bu bakteri olacak diye bir şey yok. Tabiki doktorun ve annenin tedbirini alması gerekmektedir
GBS Enfeksiyonu Bebekte Ne Zaman Ortaya Çıkıyor?
Genellikle Hamileliğin 37.inci haftasında ve doğumdan 18 saat sonra çıkar, doğumdan önce dönemde yüksek ateş veya daha önceki doğumlarında bu bakterinin yaratmış olduğu enfeksiyonun görülmesi durumda.
Bu Enfeksiyonundan Bebeğimi Nasıl Koruyabilirim?
Testiniz pozitif çıkarsa annelere korumak amacıyla antibiyotik kullanılması önerilir. Doktorunuz size en uygun antibiyotik vererek bu enfeksiyondan koruyabilir
Bu Enfeksiyon Bebeği Nasıl Etkiler?
Bu Enfeksiyon erken ve geç tip olarak iki şekildedir. Erken tip doğumdan 5 gün içinde görülmektedir. Bebekte, nefes almada zorluk, kalp atımı ve kan basıncı düzensizlik, böbreklerde problemler, hazımsızlık, zatüreye ve menenjite sebep olmaktadır. Geç tip ise doğumdan 7’nci gün ve 6 ay arasında görülmektedir. Erken tip daha ciddi bir seyir izlemektedir.




